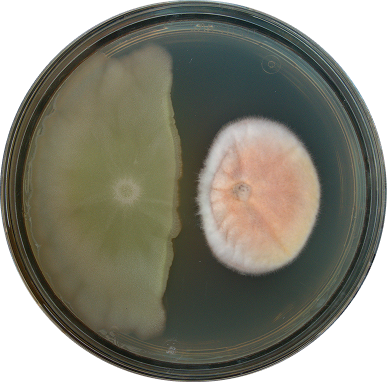
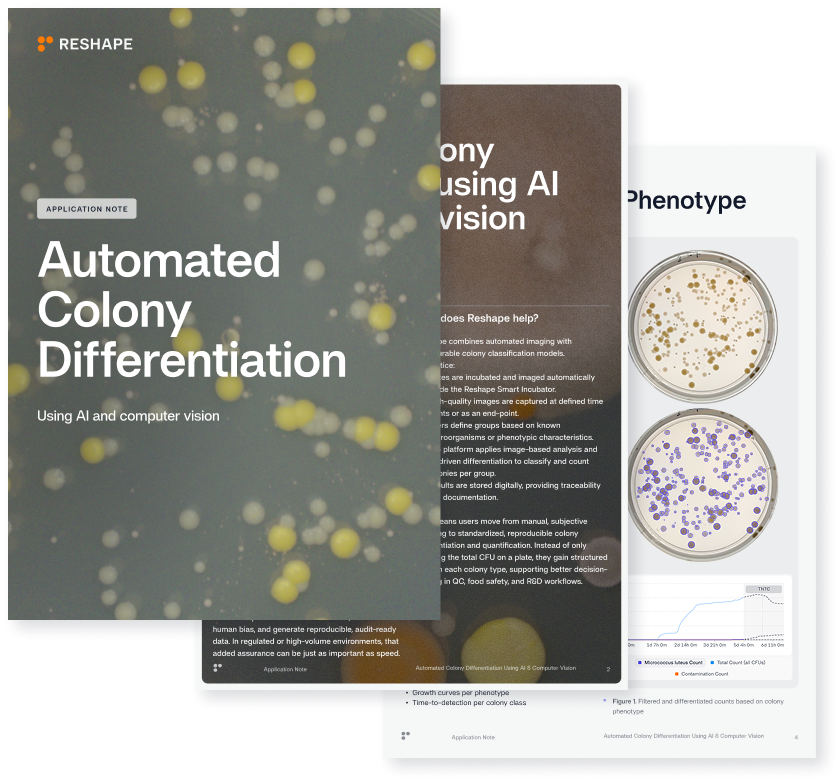

Applications
Dive deeper into how our platform can help you speed up your R&D and reach project targets reliably.


.gif)

Automated Colony Counting & Detection
Reliable QC at Scale
What we discuss:
- The workflow and value of Reshape’s automated colony counting solution for QC microbiology teams
- The value of automating a widely-used QC technique for tracking microbial growth and contamination across products
- The importance of making data fully traceable and providing more confidence in QC results
- A description of how we train, deploy and validate our AI models (with data)

Flexible R&D workflows
What we discuss:
- The workflow and value of Reshape’s automated colony counting solution for R&D microbiology teams
- The value of automating assays to improve documentation and traceability across experiments
- Explore the flexibility in colony counting methods, techniques and throughput of Reshape's platform
- A description of how we train, deploy and validate our AI models (with data)


OD Turbidity
Discover a new and high throughput way to measure turbidity.
What we discuss:
- The validity of using Reshape's platform and high-resolution imaging as a replacement for traditional laser-point OD readings
- The value of visual monitoring for aggregating-type bacteria
- Compares the growth of S.aureus and E.coli in the Reshape platform and a plate reader (with data)


Halo & Zones of Inhibition
Capture and quantify inhibition zones at the right moment.
What we discuss:
- The validity of using Reshape's automation platform and high-resolution imaging as a reliable and reproducible method for measuring zones of inhibition
- How time-lapse capture accurately measures halo zones at critical, hard-to-observe stages
- Discover how Reshape measures assays such as antibiotic disk diffusion and proteolytic activity (with data)


Radial Growth Rates
Highly accurate and time-resolved radial growth assays.
What we discuss:
- The validity of using Reshape's automation platform and high-resolution imaging as a reliable tool for measuring radial growth rates
- High-res imaging and capture rate/timelapse
- Build library and database

Antagonism
Easily observe and analyze competition dynamics between microbes on solid media.
What we discuss:
- The importance of improving traditional dual-culture assays, which are typically evaluated through manual inspection, or endpoint inhibition zone measurements that lack temporal resolution and reproducibility
- The critical need for time-resolved, objective quantification of microbial interactions
- How this transforms qualitative assays into scalable, data-driven screening workflows


Digitized Seed Scoring
Generate instant and reliable seed scoring with AI-powered high-resolution imaging.
What we discuss:
- The limitations of traditional manual seed assays for germination, health scoring, and varietal tracking, which are time-consuming, subjective, and prone to operator variability
- Manual or semi-automated approaches struggle with bias, inconsistent lighting, reflections, and limited temporal resolution, creating bottlenecks and compromising data quality
- How the Reshape Smart Incubator enables standardized, AI-driven seed analysis and how this transforms seed assays into scalable, time-resolved workflows


Automated Colony Differentiation
Detect different colonies and microbial phenotypes on a single plate.
What we discuss:
- The limitations of traditional total plate counts, which only report overall CFU and fail to distinguish between different colony types in mixed cultures, co-culture experiments, or contamination scenarios
- How the platform automatically detects, segments, classifies, and quantifies colonies based on morphology, color, size, and timing, eliminating manual tracing and subjective interpretation
- See colony counting application notes for full overview of Reshape’s capabilities